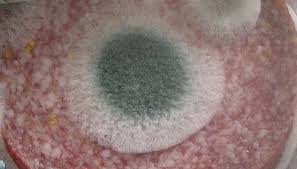
Pl�se� na sal�mu

Plísně a mikroskopické houby lze ve stručnosti charakterizovat jako organismy na pokraji rostlinné říše.
Plísně často tvoří plísňové povlaky na nejrůznějších organických látkách, předevších na nevhodně ve vlhku a teple uskladněných potravinách.
Avšak pozor, na takovéhle "chycené" marmeládě, povidlech, chlebu nebo třeba salámu nestačí jen odstranit zelený nebo bílý plísňový povlak. Řada plísní totiž vytváří člověku nebezpečné jedovaté látky, které nezůstávají uzavřeny v buňkách jejich těl, nýbrž přecházejí do okolního prostředí, kterým je v tomto případě, k naší smůle, právě potravina. Po jejím požití pak plísní do potraviny vyloučené jedovaté látky mohou poškodit některé orgány lidského těla - především játra a ledviny.
Některé plísně však mohou být za určitých okolností pro člověka dokonce i užitečné, protože produkují penicilin, který funguje jako antibiotikum, nepříliš jedovaté pro člověka, avšak velice jedovaté pro choroboplodné zárodky, které dokáže ničit. Penicilin je tedy vítaným prostředkem proti některým bakteriím. Bylo by však omylem myslet si, že zplesnivělý chléb by mohl nahradit penicilin.
Další tzv. ušlechtilé plísně člověk využívá při výrobě "plesnivých" sýrů a dalších potravin. Jedná se o druhy plísní, které dokážou vylepšit chuťové vlastnosti některých potravin a nevylučují do nich přitom jedovaté látky.
Další články:
Pět smyslů člověka je spojovacím článkem mezi světem a mozkem.
Severočeský zámek Ploskovice pochází z šestnáctého století.
Hrabavý pták orebice horská pochází z jihovýchodní Evropy.
Romantický zámek Žleby již několikrát využili filmoví tvůrci.
Vodní zámek Blatná obklopuje zámecký park.
Statná jednoletá rostlina kukuřice setá může v příznivých podmínkách dorůstat až čtyřmetrové výšky.
Metoda šalování se používá ve stavebnictví.
12. dubna 1961 se objevil jako první člověk ve vesmíru Jurij Alexejevič Gagarin.
Nepříjemná plíseň na potravinách se dokáže objevit náhle a nečekaně.
Kaštanovník setý nebo lidově jedlý kaštan, plodí jedlé plody.
Klasicistní zámek Korozluky stojí na jižním svahu Jánského vrchu.
Bylina koriandr setý roste do výšky 70 až 100 centimetrů.
Plísně a člověk žijí vedle sebe již od pradávných časů.